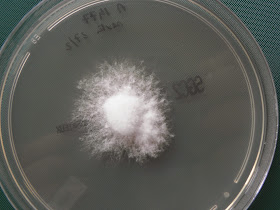

O Schizophyllum commune é um fungo ubiquitário que é frequentemente encontrado adjacente às raízes das plantas. Em micologia médica está associado a sinusites (como é o caso desta estirpe) e a episódios alérgicos bronco-pulmonares.
É isolado a partir da cultura, em meio de Sabouraud, de secreções e ou material de biópsia dos seios paranasais e árvore respiratória superior.
O significado clínico do isolado é muito importante já que pode dar origem a infecções fungicas de carácter invasivo com destruição do osso subjacente e invasão de estruturas anatómicas circundantes com graves consequências.
Em 2003 um artigo cientifico de Buzina W e al. revelou através de testes moleculares a presença do S. commune em 12 dos 230 doentes com rinosinusite crónica/bola fungica estudados
É frequente observar-se, pela parte da otorrinolaringologia, uma abordagem incompleta à situação clínica: limitam-se a uma manipulação exclusivamente cirúrgica com extracção da massa visível para efeitos de desobstrução das vias aéreas, o que é conseguido de imediato fazendo com que a sintomatologia predominante desapareça com grande satisfação do paciente. Por outro, lado muitas vezes, o doente pode recorrer em primeiro lugar ao imunoalergologista devido à sintomatologia alérgica e este faz uma abordagem estritamente farmacológica no sentido de resolver a sintomatologia.
Em ambos os casos, a maior parte das vezes, e até porque o laboratório de micologia médica não foi capaz de isolar/identificar o fungo ou nem sequer foi consultado, a terapêutica antifungica adequada que deveria acompanhar e completar os procedimentos cirúrgicos não é instituida e o problema (a presença do fungo) permanece dando lugar a recidivas do quadro clínico
O Schizophyllum commune é um microrganismos cuja classificação gera alguma controvérsia. Pertence à divisão dos oomycotas classe basidiomycetes
É isolado a partir da cultura, em meio de Sabouraud, de secreções e ou material de biópsia dos seios paranasais e árvore respiratória superior.
O significado clínico do isolado é muito importante já que pode dar origem a infecções fungicas de carácter invasivo com destruição do osso subjacente e invasão de estruturas anatómicas circundantes com graves consequências.
Em 2003 um artigo cientifico de Buzina W e al. revelou através de testes moleculares a presença do S. commune em 12 dos 230 doentes com rinosinusite crónica/bola fungica estudados
É frequente observar-se, pela parte da otorrinolaringologia, uma abordagem incompleta à situação clínica: limitam-se a uma manipulação exclusivamente cirúrgica com extracção da massa visível para efeitos de desobstrução das vias aéreas, o que é conseguido de imediato fazendo com que a sintomatologia predominante desapareça com grande satisfação do paciente. Por outro, lado muitas vezes, o doente pode recorrer em primeiro lugar ao imunoalergologista devido à sintomatologia alérgica e este faz uma abordagem estritamente farmacológica no sentido de resolver a sintomatologia.
Em ambos os casos, a maior parte das vezes, e até porque o laboratório de micologia médica não foi capaz de isolar/identificar o fungo ou nem sequer foi consultado, a terapêutica antifungica adequada que deveria acompanhar e completar os procedimentos cirúrgicos não é instituida e o problema (a presença do fungo) permanece dando lugar a recidivas do quadro clínico
O Schizophyllum commune é um microrganismos cuja classificação gera alguma controvérsia. Pertence à divisão dos oomycotas classe basidiomycetes
Oomycota ou pseudo-fungos são um grupo de microrganismos filamentosos que em cultura se assemelham a fungos, são poucas as espécies deste grupo que estão descritas como patogénicas no ser humano.
Basidiomycetes são um grupo de microrganismos que produzem esporos numa estrutura em forma de bastão. Podem ser encontrados quer na forma leveduriforme (uni-celular) quer na forma micelar.
O S. commune é estritamente micelar (filamentoso).
As colónias são grandes, de crescimento rápido, brancas e com textura algodonosa. No nosso isolado a cultura teve uma fase inicial de crescimento lento a que se seguiu uma fase de crescimento explosivo (talvez por ter sido manuseada). A colónia poderá gerar estruturas reprodutoras visíveis a olho nu. Fragmentos de biópsia previamente incubados em meio líquido tiveram culturas negativas (por regra quando se pesquisam fungos é de evitar meios líquidos)
Ao exame microscópico as hifas são septadas, hialinas e largas, podem apresentar na zona do septo conexões denominadas gancho ou fíbula (clamp em inglês) e ainda espículas. Os ganchos podem não aparecer se a estirpe for monocariotica.
Qualquer fungo isolado em secreções ou em biópsias dos seio paranasais que seja branco, algodonoso, de crescimento rápido, com hifas septadas, com ausência de esporos e que seja sensível à cicloheximida deve levantar a suspeita de ser S. commune.
|
| Após 5 dias de incubação. |
 |
| Após 7 dias de incubação. |
 |
| Após 10 dias de incubação. |
 |
| Colónias com mais de 30 dias de cultura à temperatura ambiente. |
 |
| Colónias com mais de 30 dias de cultura à temperatura ambiente. |
 |
| Colónias com mais de 30 dias de cultura à temperatura ambiente. "Fruiting bodies" |
Outra estirpe:
 |
| Colónia com 20 dias de incubação. |
 |
| Hifas com espículas. |
 |
| Setas indicam hifas com espículas, objectiva de imersão - 100x |
 |
| Objectiva de imersão 100x. Setas vermelhas indicam espículas, seta amarela mostra gancho. |
 |
| Objectiva de imersão 100x. Setas vermelhas indicam espículas, setas amarelas mostra gancho. |
 |
| Objectiva de imersão 100x. Setas vermelhas indicam espículas, seta amarela mostra gancho. |
 |
| Objectiva de imersão 100x. Setas vermelhas indicam espículas, setas amarelas mostra gancho. |


















